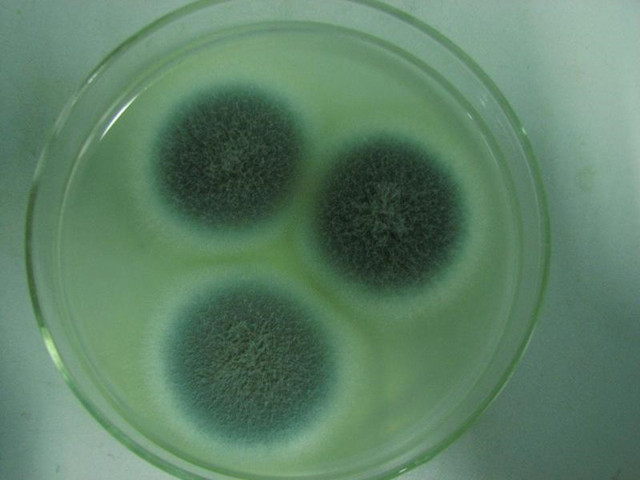
橘子发霉后提取青霉素的原始方法,霉变橘子上的青霉素是什么

相传在唐朝时,长安城的裁缝会把长有绿毛的糨糊涂在被剪刀划破的手指上,以此来帮助伤口愈合。现在的人们知道,这种“绿毛”其实是青霉菌,它能够产生一类名为青霉素的抗生素,可用来杀菌。

直接使用“绿毛”来消炎是十分危险的,不知道那位裁缝最后怎么样了......青霉菌的种类很多,对应的青霉素种类也很多,但并不是所有的青霉素都能在人类身上使用,例如长有青毛的橘子上产生的一种青霉素——展青霉素,却是一种强力的毒药。
青霉病主要由青霉菌侵染引起,包括扩展青霉 、橘青霉、黄绿青霉、圆弧青霉 、意大利青霉等,其中扩展青霉是引起多种水果发生青霉病害的主要病原菌之一。

青霉菌
扩展青霉在生长代谢过程中会产生一种名为“展青霉素”的物质,最初是在20世纪40年代被作为一种抗生素被分离而得,那时人们发现它是一种广谱性的抗菌毒素,对75种以上的细菌都有抑制作用!后来一系列的研究表明,展青霉素不仅对真菌和细菌有毒性,还对动物和高等植物,包括黄瓜、小麦、豌豆、玉米及亚麻等均表现出毒性。
大量研究表明,展青霉素可引发一系列的急症、慢性病症,以及细胞水平的病变。摄入展青霉素而引发的急性病症可能导致出现兴奋、抽搐、呼吸困难、肺肿、水肿、溃疡、充血、胃肠道胀气、肠道出血、上皮细胞恶化、肠炎、呕吐,以及其他胃肠道及肾脏损伤。摄入展青霉素引发的慢性病症可能产生神经毒性、免疫毒性、免疫抑制性、基因毒性、致畸性和致癌性作用,对人类健康存在着强烈威胁。
培养基中的青霉菌
展青霉素,也被称为棒曲霉素,是一种有毒的真菌次级代谢产物,它可由青霉属、曲霉属和丝衣霉属等多种真菌产生,在自然环境下,扩展青霉是主要产毒菌株。在世界范围内展青霉素是一种常见的水果污染物,在多种水果及其制品中均有发现,尤其是苹果及其制品中。
青霉素是人类发现的第一种抗生素,上世纪40年代用于临床,对于人类的作用无疑是巨大的,它主要包括以下这些:

而有一些青霉菌产生的毒素并不能为人类所用,例如,黄绿青霉、桔青霉和岛青霉能引起大米霉变,产生“黄变米”,它们产生的毒素如黄绿青霉素对动物神经系统有损害,桔青霉素能损害肾,岛青霉产生的黄天精、环氯素和岛青霉素均为肝*毒脏**。

有多少人和我一样,在知道长满绿毛的橘子上有青霉素而异常兴奋,想要涂在伤口上?了解了展青霉素后,果断放弃了这种想法......